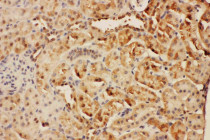

ARG58431
anti-CISH / Cis 1 antibody
anti-CISH / Cis 1 antibody for IHC-Formalin-fixed paraffin-embedded sections and Human,Rat
Overview
| Product Description | Rabbit Polyclonal antibody recognizes CISH / Cis 1 |
|---|---|
| Tested Reactivity | Hu, Rat |
| Predict Reactivity | Hm |
| Tested Application | IHC-P |
| Host | Rabbit |
| Clonality | Polyclonal |
| Isotype | IgG |
| Target Name | CISH / Cis 1 |
| Antigen Species | Human |
| Immunogen | Synthetic peptide corresponding to a sequence at the C-terminus of Human CISH(241-258aa LPLPRRMADYLRQYPFQL), identical to the related Rat and Mouse sequences. |
| Conjugation | Un-conjugated |
| Alternate Names | BACTS2; CIS-1; CIS; SOCS; Protein G18; G18; Suppressor of cytokine signaling; Cytokine-inducible SH2-containing protein |
Application Instructions
| Application Suggestion |
|
||||
|---|---|---|---|---|---|
| Application Note | IHC-P: Antigen Retrieval: By heat mediation. * The dilutions indicate recommended starting dilutions and the optimal dilutions or concentrations should be determined by the scientist. |
Properties
| Form | Liquid |
|---|---|
| Purification | Affinity purification with immunogen. |
| Buffer | 0.9% NaCl, 0.2% Na2HPO4, 0.05% Thimerosal, 0.05% Sodium azide and 5% BSA. |
| Preservative | 0.05% Thimerosal and 0.05% Sodium azide |
| Stabilizer | 5% BSA |
| Concentration | 0.5 mg/ml |
| Storage Instruction | For continuous use, store undiluted antibody at 2-8°C for up to a week. For long-term storage, aliquot and store at -20°C or below. Storage in frost free freezers is not recommended. Avoid repeated freeze/thaw cycles. Suggest spin the vial prior to opening. The antibody solution should be gently mixed before use. |
| Note | For laboratory research only, not for drug, diagnostic or other use. |
Bioinformation
| Database Links |
Swiss-port # Q9NSE2 Human Cytokine-inducible SH2-containing protein |
|---|---|
| Gene Symbol | CISH |
| Gene Full Name | cytokine inducible SH2-containing protein |
| Background | The protein encoded by this gene contains a SH2 domain and a SOCS box domain. The protein thus belongs to the cytokine-induced STAT inhibitor (CIS), also known as suppressor of cytokine signaling (SOCS) or STAT-induced STAT inhibitor (SSI), protein family. CIS family members are known to be cytokine-inducible negative regulators of cytokine signaling. The expression of this gene can be induced by IL2, IL3, GM-CSF and EPO in hematopoietic cells. Proteasome-mediated degradation of this protein has been shown to be involved in the inactivation of the erythropoietin receptor. Multiple transcript variants encoding different isoforms have been found for this gene. [provided by RefSeq, Aug 2008] |
| Function | SOCS family proteins form part of a classical negative feedback system that regulates cytokine signal transduction. CIS is involved in the negative regulation of cytokines that signal through the JAK-STAT5 pathway such as erythropoietin, prolactin and interleukin 3 (IL3) receptor. Inhibits STAT5 trans-activation by suppressing its tyrosine phosphorylation. May be a substrate-recognition component of a SCF-like ECS (Elongin BC-CUL2/5-SOCS-box protein) E3 ubiquitin-protein ligase complex which mediates the ubiquitination and subsequent proteasomal degradation of target proteins (By similarity). [UniProt] |
| Calculated MW | 29 kDa |
| PTM | Association with EPOR may target the protein for proteolysis by the ubiquitin-dependent proteasome pathway. CIS is mainly monubiquitinated (37 kDa form) but may also exist in a polyubiquitinated form (45 kDa). [UniProt] |
Images (2) Click the Picture to Zoom In
-
ARG58431 anti-CISH / Cis 1 antibody IHC-P image
Immunohistochemistry: Paraffin-embedded Human lung cancer stained with ARG58431 anti-CISH / Cis 1 antibody.
-
ARG58431 anti-CISH / Cis 1 antibody IHC-P image
Immunohistochemistry: Paraffin-embedded Rat kidney stained with ARG58431 anti-CISH / Cis 1 antibody.